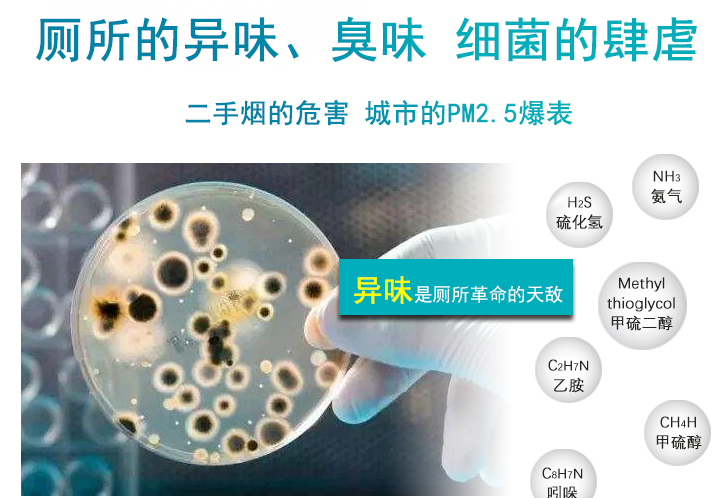
公廁除臭機

公廁除臭機,公共廁所除臭有方 技術動態 眾所周知,但凡是那些建在醫院、學校、商場、市場、景區以及機場、車站、地鐵站、高速公路服務區等公共場所的公共廁所、衛生間,每天的人流量是非常大的,如若清潔打掃不及時,那么就會導致臭味濃烈、?味繁雜、臟亂差等現象嚴重;為此,公共廁所、衛生間除臭和衛生問題,一直是現今各大城市環衛部門都急需解決的難題!
城市公共廁所、衛生間衛生標準值:公共衛生間是生物循環與城市發展不可缺少的交匯點。因此,衛生部也針對城市公共衛生間制訂了《GB/T 17217—1998城市公共廁所衛生標準》,對城市公共衛生間的環境衛生提出了規范和要求,同時也是指導公共衛間間環境管理的一個重要依據。
目前,全國各大城市大部分公共廁所、衛生間除臭仍舊采用傳統的方法,大致分為檀香除臭、通風除臭、清新劑除臭、植物除臭、活性炭除臭等方式,然而此類除臭方法只是簡單停留在淡化異味階段,卻并沒有從本質上消除異味以及它對人體健康產生的危害。

現如今,隨著人力成本的不斷提升,單靠人工,通過頻率較高的工作形式去實現廁所除臭治理,已經力不從心,過程管理難以面面俱到。為了快速推進公廁空氣環境治理,正島電器研發了正島公共廁所除臭設備ZY-1800壁掛式公廁除臭機,實現整體美觀、簡單有效地進行廁所除臭,降低安全隱患,又能提升城市窗口展示的整體形象。
正島公共廁所除臭設備ZY-1800壁掛式公廁除臭機,具有◎高效除臭◎殺菌滅蚊◎節約成本◎超細霧滴◎節省人工等諸多優勢,注入中性除味劑可自動為酒店、商場、寫字樓、廁所等空間除味,注入中性消毒水可為室內自動消毒,注入自來水可為場所空氣自動加濕。

正島公共廁所除臭設備ZY-1800壁掛式公廁除臭機,控制方式采用數字時序控制器自動循環控制,自動循環控制周期由一秒鐘到九十九分鐘五十九秒,可任意設置工作時間及停止時間,設定好后可連續工作,無需人員職守;配有5.5公斤水容量的自備水箱,水箱上端連接有注水口,下端配有放水開關,操作簡單、維護方便!歡迎您來咨詢公廁除臭機,公共廁所除臭有方的詳細信息!
正島公共廁所除臭設備ZY-1800壁掛式公廁除臭機控制方式及技術參數:

正島公共廁所除臭設備ZY-1800壁掛式公廁除臭機箱體采用全不銹鋼材質,表面噴塑處理,此舉既保證了外形美觀大方又滿足了設備防腐的要求。內部采用六振子集成式霧化組件,并配有無水保護裝置,所產生的霧粒直徑只有 小于10μm,顆粒均勻,能長時間懸浮于空氣當中??筛鶕嶋H需要連接⊙75mm的PVC管路,其傳輸距離可在5-8米左右。
正島公共廁所除臭設備ZY-1800壁掛式公廁除臭機安裝方法:
(1)安裝地點:安裝在公廁的墻壁上。
(2)除臭機器安裝距離地面在2.5米左右為佳。

正島公共廁所除臭設備ZY-1800壁掛式公廁除臭機使用說明:
(1)首次使用通過24小時(噴灑使用總時間合計在30分鐘以上)不間斷向公廁區噴灑使用生物除臭劑,確保凈化消毒房間達到處理效果,經過連續2-3天處理后公廁室內空氣即可基本達到無異味。
(2)日常使用維護:全自動定時噴霧,每半月一檢。
2.2.4、 除臭凈化效果:經過3-5天處理后各項臭氣污染指標比處理前均有明顯降低,綜合評價結果達到:公共廁所空氣凈化臭氣濃度達到國標GB14554-93《惡臭污染物排放標準》中的二級標準。

正島公共廁所除臭設備ZY-1800壁掛式公廁除臭機除臭優點:
(1)本設備配合植物除臭抑菌劑,可以有效消除廁所內的異味。
(2)除臭抑菌劑迅速擴散在廁所當中,能在整個空間里充滿,抑制異味的產生。
(3)直觀的霧化效果,迅速的分解消殺作用
(4)可控的時間循環運轉,無藥保護功能,可以保證除臭設備的有效運行。

綜上所述:比起過去聞著味兒就能找到廁所的情況,如今,各大城市的公共廁所可以說是又氣派又干凈。可一旦人氣太旺,刺鼻的“廁所味”還是難以解決。為了徹底解決公廁除臭難這個問題啊,越來越多城市的環衛部門在醫院、學校、商場、市場、景區以及機場、車站、地鐵站、高速公路服務區等公共場所的公共廁所、衛生間都安裝了正島公共廁所除臭設備ZY-1800壁掛式公廁除臭機。

與以往點檀香除臭、通風除臭、清新劑除臭、植物除臭、活性炭除臭等方式相比,正島公共廁所除臭設備ZY-1800壁掛式公廁除臭機里內置安全環保的純天然綠色植物除臭液,在機器告訴運作下,極其微小的除味粒子飄散空中,與異味分子中和降解,并散發出自然清香的味道。由于空氣質量得到改善,蚊蠅也大大減少,良好的如廁環境,反而吸引了著不少市民不惜繞路來“體驗”,全面提升文明城市水平。以上關于公廁除臭機,公共廁所除臭有方的全部相關信息是正島電器提供的,以供大家參考學習!



